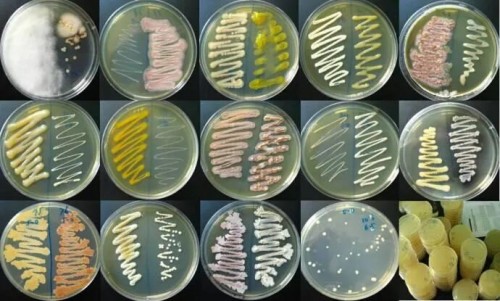

1929 年,青霉素被发现,这是现代医学史上具有重大历史意义的节点。自那以后,以青霉素为代表的抗生素拯救了无数生命,而当年发现的青霉素极其少量,根本不可能支撑起巨大的需求。抗生素、胰岛素等现代医疗中极其重要的产品是微生物的代谢产物,而它们的大规模工业生产的背后,是微生物工程乃至生物产业的飞速发展。
事实上,微生物在生活中无处不在,我们指的当然并不仅仅是物理意义上的。我们每天吃的面包、酱油、啤酒、味精等等各类食品背后,都是微生物的发酵作用;我们平常穿的衣服、用的清洁用品等等,在工业生产中都用到了酶制剂,其背后同样离不开性状优良的微生物菌种。
(来源:网络)
可以说,菌种是生物产业的命脉和核心竞争力,是生物企业技术创新和提高竞争力的有力保障,常常被称为是生物产业的“芯片”。微生物育种、高通量筛选技术与装备创新不仅是国内外科技前沿,也是推动生物产业发展的核心动力。然而,我国的微生物育种技术与装备水平和综合能力较发达国家有很大差距,成为生物产业发展的“卡脖子”环节,这一情况,与实际的芯片半导体行业如出一辙。
不过,近年来新型高效诱变、精准基因编辑和基因组工程、合成生物学及高通量筛选等新技术的不断革新和应用拓展,为微生物育种效率和水平的大幅提升带来了革命性的机遇。
诱变育种是以人工诱变手段诱变微生物发生基因突变,作为微生物育种中人工选育下应用最为广泛的育种技术,具有速度快、收益大、方法简单等优点,但其缺点在于缺乏基因突变定向性,结果随机性大,需要配合大规模的筛选工作方能收到良好的效果。传统的诱变手段主要分为物理诱变、化学诱变和复合诱变技术,而随着分子生物学的发展,出现了诸如离子注入诱变法等创新技术,效率更高的同时却也面临着对真空环境要求严格、容易导致微生物死亡等问题,亟需改进;而近几年才兴起的 ARTP(Atmospheric and Room Temperature Plasma)常压室温等离子体诱变系统性能更为优良,具有成本低、操作方便、获得突变型多样性更大、无毒无害等独特优点,已经成为当前一个相当活跃的交叉学科研究领域,未来不可限量。

(来源:资料)
自 2012 年 CRISPR-Cas9 问世以来,基因编辑技术大热,进入爆炸式发展时期。国外对于基因编辑基础核酸酶的研究早于国内,且进行了全方面的国际化专利布局保护,以核心技术 CRISPR-Cas 为例,当今全球共有 6 种具备编辑活性的 Cas 酶,其中以 Cas9 为代表的 4 种 由美国掌握。不过中国农业大学赖锦盛教授开发的新型 DNA 编辑系统包括 Cas12i.3,Cas12j.19,Cas3C 等,前两者可用于生物育种,且已经在 2021 年获得国家专利授权,并向美国、欧盟、日本等多个国家递交了专利申请。微生物育种从自然随机筛选(自然选育)、人为随机突变(诱变育种)到定向随机突变(基因重组),再到精准基因编辑,是一个不断接近靶向的发展过程。以 CRISPR 为代表的基因编辑技术作为现代遗传学研究的热点技术,极大地提升了现代工业微生物育种的效率,有着成本低、周期短、靶向精确、产品管线丰富、节约资源等突出优点,是育种技术的里程碑式发展。

(来源:资料)
微生物育种中,有着“突变仅是前提,筛选才是关键”的说法,可见菌种筛选的重要性,而高通量筛选意味着效率的极大提升。多孔板(MTP)筛选系统和流式细胞术(FACS)是常用的筛选手段,但 MTP 通量较低,而 FACS 难以用于检测胞外分泌的代谢物。液滴微流控技术在微生物育种领域的应用,成功实现了大容量突变库的全面评价以及高效筛选,不仅在筛选通量方面实现了大幅度提升,有效提高了菌株选育工作效率,而且在筛选成本方面也展现出巨大优势,可显著降低筛选过程中试剂耗材的用量,将单克隆的筛选成本降低至十分之一或百分之一,实现高通量、低消耗的优良工业菌株选育,越来越成为科研以及工业生产的重要技术手段。

(来源:资料)
在这样的局面和机遇下,为增强生物产业微生物育种技术领域“产学研”各界的沟通与交流,推动该领域产学研合作,促进我国生物产业发展,兹定于 2022 年 11 月 18~20 日在江苏省无锡市召开“第九届微生物育种工程与应用评价研讨会暨中国生物发酵产业协会微生物育种分会第六次学术会议”。本次会议将聚焦微生物育种前沿领域的新方法、新技术和新的应用成果,主要包括:工业酶制剂、发酵食品、生物医药等领域的工业菌株改造技术与应用研究成果;合成途径设计与构建、精准基因编辑、基因组工程等合成生物学等新理论在菌种选育中的应用;基于微流控、高通量谱学等技术开发的微生物高通量进化与筛选装备的进展等领域,以覆盖菌种选育全流程的先进技术和产业下游不断涌现的多种应用场景。
会议原名“生物育种暨高通量筛选技术理论与应用研讨会”,自 2012 年由天木生物发起开始,已在石家庄、无锡、洛阳、福州、成都、芜湖等地成功举办八届,已经成为了生物育种领域享有盛名的系列学术研讨会之一。历届会议规模 200 人以上,汇聚业界精英,专家报告精彩, 代表交流热烈,真正为企业及技术人员和科研单位与科研人员之间搭建了深入沟通的桥梁,与会代表反响良好。2022 年,主办方之一的中国生物发酵产业协会为满足新时期生物产业发展需求,将微生物育种分会更名为微生物育种工程与应用评价分会。

▲图丨历届会议情况(来源:资料)
本次会议由中国生物发酵产业协会、清华大学工业生物催化教育部重点实验室、清华大学无锡应用技术研究院生物育种研究中心联合主办,由无锡源清天木生物科技有限公司、北京聚树生物科技有限公司、北京演绎科技有限公司(DeepTech)、安徽省工业微生物分子育种工程实验室承办,将邀请学术界和产业界的知名专家、学者、企业家与资深技术人员齐聚无锡滨湖,共同深入探讨微生物育种与高通量筛选的新技术、新方法、新装备和生物育种领域的发展新动态。
欢迎关注Deeptech公众号了解详情,报名参会!









找产品
招代理商
找工作
查数据




